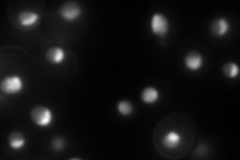
YNL175C
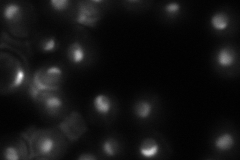
YNL175C

View description
Nucleolar protein found in preribosomal complexes; contains an RNA recognition motif (RRM)
Localization:
Intensity:
Fold change:
Significance:
-
C’ GFP library in SD

nucleus72.4 -
N' NOP1pr-GFP in SD
nuclear periphery168.738 -
N' TEF2pr-mCherry in SD

nucleus,nucleolus250.728 -
N' NATIVEpr-GFP in SD
nucleus95.6289 -
N' TEF2pr-VC and Cyto-VN in SD

#N/A0 -
C’ GFP library in SD+DTT

nucleus45.480.62Yes -
C’ GFP library in SD+H2O2

nucleus72.270.99No -
C’ GFP library in Starvation Media

nucleusN/AN/AYes -
C’ GFP library on the background of Pup2-DaMP

N/A -
C’ GFP library on the background of CCT mutant

N/A0N/AYes
